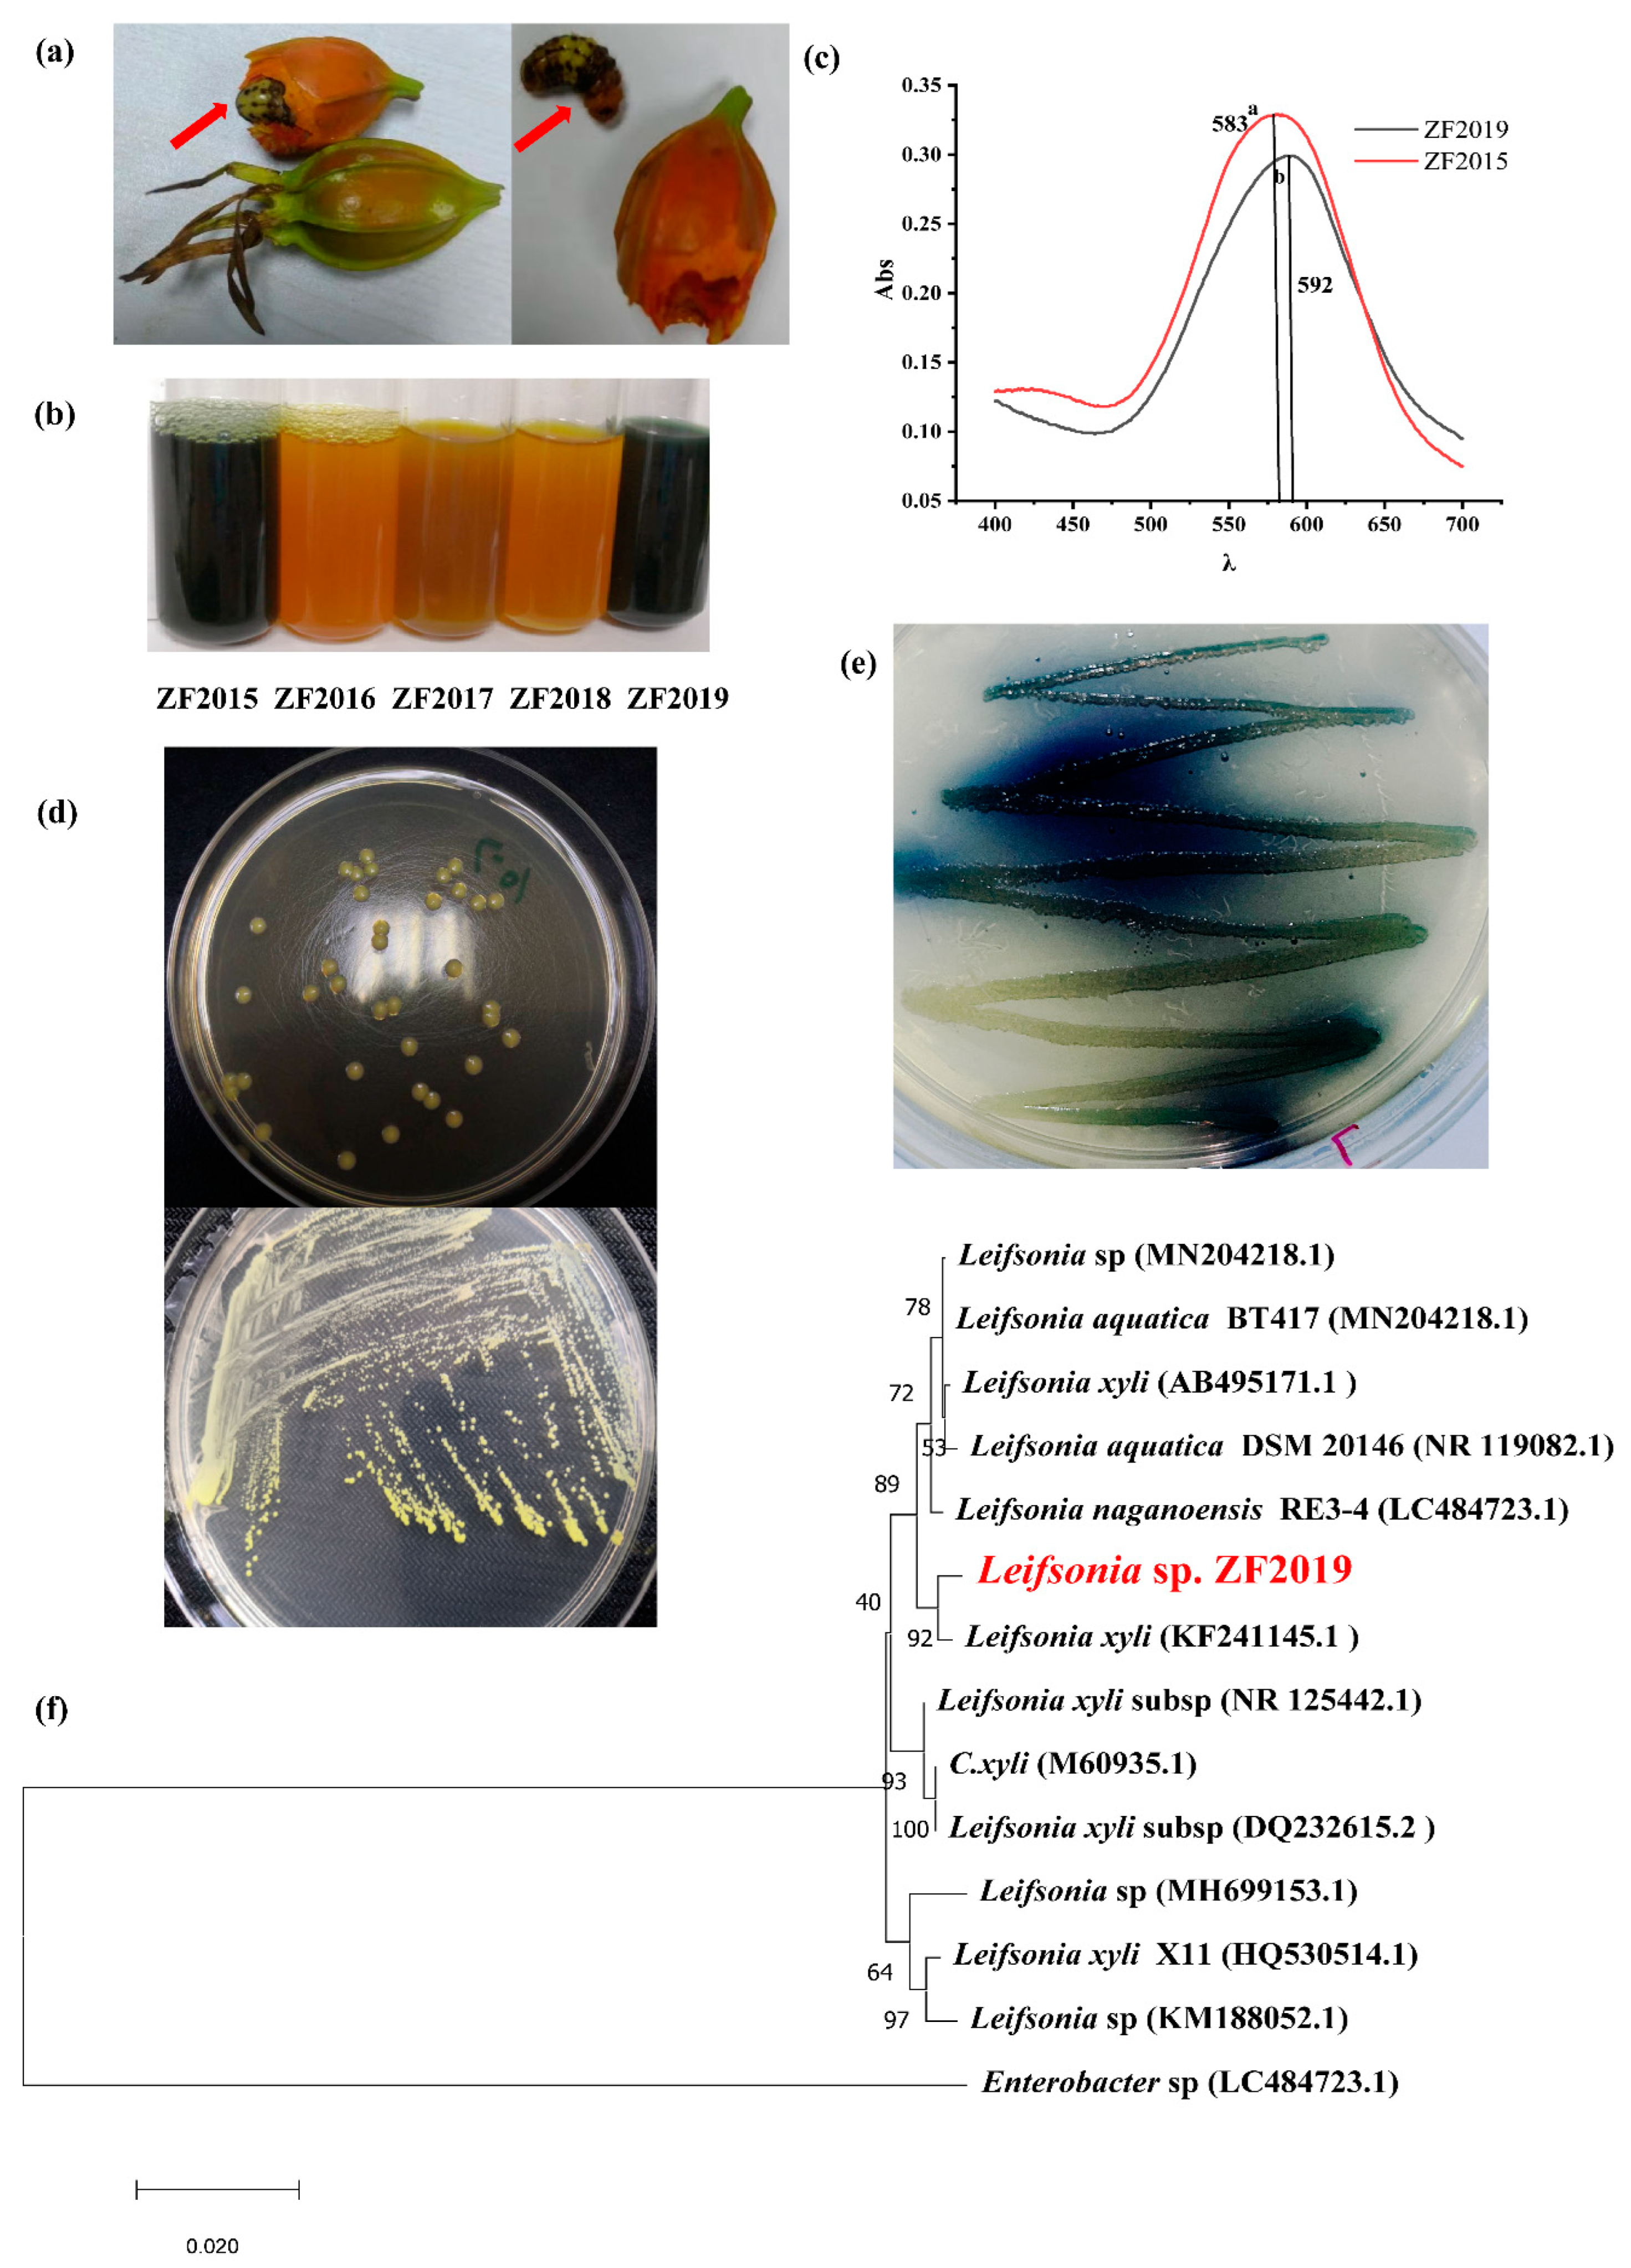

Transformation of Gardenia Yellow Waste Production into Gardenia Blue Pigment by Leifsonia sp. ZF2019 and Evaluation of Its Physicochemical Stability
Abstract
:1. Introduction
2. Materials and Methods
2.1. Materials and Chemicals
2.2. Bacteria Isolation and Identification
2.3. HPLC Analysis
2.4. Effect of Carbon or Nitrogen Resources, Leu Concentrations, pH, and Incubation Times on the Gardenia Blue Yield and the Rates of Geniposide Transformation to Genipin
2.5. GBP Preparation
2.6. Screening of Macroporous Adsorbent Resins for GBP Purification
2.7. GBP Purification with Macroporous Adsorbent Resins
2.8. Comparison of the Yield and Quality of GBP Produced by Leifsonia sp. ZF2019 and Aspergillus niger
2.9. Effects of pH, Temperature, Light, and Additive Type on the Stability of GBP
2.10. LC-MS Analysis
2.11. Statistical Analysis
3. Results and Discussion
3.1. Leifsonia sp. ZF2019 Strain Isolation and Identification
3.2. Influences of Amino Acid Type, C, and N Resources on the GBP Product by Leifsonia sp. ZF2019
3.3. Antioxidant and Hepatoprotective Activity and the Influence of Leu Concentration, pH, and Fermentation Time on the GBP Produced by Leifsonia sp. ZF2019
3.4. GBP Purification by Macroporous Adsorption Resins
3.5. Comparison of GBP Fermentation by Leifsonia sp. ZF2019 and Aspergillus niger
3.6. Effects of pH, Temperature, and Light on GBP Physical Stability
3.7. Effects of Different Types of Additives on GBP Physical Stability
3.8. Molecular Formula Analysis
4. Conclusions
Supplementary Materials
Author Contributions
Funding
Institutional Review Board Statement
Informed Consent Statement
Data Availability Statement
Conflicts of Interest
References
- Oplatowska-Stachowiak, M.; Elliott, C.T. Food colors: Existing and emerging food safety concerns. Crit. Rev. Food Sci. Nutr. 2017, 57, 524–548. [Google Scholar] [CrossRef] [PubMed]
- Sigurdson, G.T.; Tang, P.; Giusti, M.M. Natural colorants: Food colorants from natural sources. Annu. Rev. Food Sci. Technol. 2017, 8, 261–280. [Google Scholar] [CrossRef] [PubMed]
- Sun, L.; Xin, F.; Alper, H.S. Bio-synthesis of food additives and colorants-a growing trend in future food. Biotechnol. Adv. 2021, 47, 107694. [Google Scholar] [CrossRef] [PubMed]
- Rodriguez-Amaya, D.B. Update on natural food pigments—A mini-review on carotenoids, anthocyanins, and betalains. Food Res. Int. 2019, 124, 200–205. [Google Scholar] [CrossRef]
- Olas, B.; Białecki, J.; Urbańska, K.; Bryś, M. The effects of natural and synthetic blue dyes on human health: A review of current knowledge and therapeutic perspectives. Adv. Nutr. Bethesda Md. 2021, 12, 2301–2311. [Google Scholar] [CrossRef]
- Paik, Y.; Lee, C.; Cho, M.; Hahn, T. Physical stability of the blue pigments formed from geniposide of gardenia fruits: Effects of pH, temperature, and light. J. Agric. Food Chem. 2001, 49, 430–432. [Google Scholar] [CrossRef]
- Newsome, A.G.; Culver, C.A.; van Breemen, R.B. Nature’s palette: The search for natural blue colorants. J. Agric. Food Chem. 2014, 62, 6498–6511. [Google Scholar] [CrossRef]
- Prado, J.M.; Veggi, P.C.; Náthia-Neves, G.; Meireles, M.A.A. Extraction methods for obtaining natural blue colorants. Curr. Anal. Chem. 2020, 16, 504–532. [Google Scholar] [CrossRef]
- Lee, S.-W.; Lim, J.-M.; Bhoo, S.-H.; Paik, Y.-S.; Hahn, T.-R. Colorimetric determination of amino acids using genipin from Gardenia jasminoides. Anal. Chim. Acta 2003, 480, 267–274. [Google Scholar] [CrossRef]
- He, Y.; Wang, C.X.; Jiao, R.H.; Ni, Q.X.; Wang, Y.; Gao, Q.X.; Zhang, Y.Z.; Xu, G.Z. Biochemical characterization of a novel glucose-tolerant GH3 β-glucosidase (Bgl1973) from Leifsonia sp. ZF2019. Appl. Microbiol. Biotechnol. 2022, 106, 5063–5079. [Google Scholar] [CrossRef]
- Neri-Numa, I.A.; Pessoa, M.G.; Paulino, B.N.; Pastore, G.M. Genipin: A natural blue pigment for food and health purposes. Trends Food Sci. Technol. 2017, 67, 271–279. [Google Scholar] [CrossRef]
- de Miranda Sabino, C.V.; Paula da Silva, B.J.; de Menezes, D.L.B.; Araújo da Silva, F.M.; de-Souza, T.P.; Henrique Ferreira Koolen, H.; de Lima Á, A.N.; Silva Lima, E. Physicochemical characterization, stability and cytotoxicity of a blue dye obtained from Genipap fruit (Genipa americana L.). Food Technol. Biotechnol. 2021, 59, 103–111. [Google Scholar] [CrossRef]
- Brauch, J.E.; Zapata-Porras, S.P.; Buchweitz, M.; Aschoff, J.K.; Carle, R. Jagua blue derived from Genipa americana L. fruit: A natural alternative to commonly used blue food colorants? Food Res. Int. 2016, 89 Pt 1, 391–398. [Google Scholar] [CrossRef] [PubMed]
- Hobbs, C.A.; Koyanagi, M.; Swartz, C.; Davis, J.; Maronpot, R.; Recio, L.; Hayashi, S.M. Genotoxicity evaluation of the naturally-derived food colorant, gardenia blue, and its precursor, genipin. Food Chem. Toxicol. 2018, 118, 695–708. [Google Scholar] [CrossRef] [PubMed]
- Li, K.D.; Yan, K.; Wang, Q.S.; Tian, J.S.; Xu, D.; Zhang, W.Y.; Cui, Y.L. Antidepressant-like effects of dietary gardenia blue pigment derived from genipin and tyrosine. Food Funct. 2019, 10, 4533–4545. [Google Scholar] [CrossRef]
- Chen, L.P.; Li, M.X.; Yang, Z.Q.; Tao, W.D.; Wang, P.; Tian, X.Y.; Li, X.L.; Wang, W.G. Gardenia jasminoides Ellis: Ethnopharmacology, phytochemistry, and pharmacological and industrial applications of an important traditional Chinese medicine. J. Ethnopharmacol. 2020, 257, 112829. [Google Scholar] [CrossRef]
- Li, N.; Fan, M.C.; Li, Y.; Qian, H.F.; Zhang, H.; Qi, X.G.; Wang, L. Stability assessment of crocetin and crocetin derivatives in gardenia yellow pigment and gardenia fruit pomace in presence of different cooking methods. Food Chem. 2020, 312, 126031. [Google Scholar] [CrossRef]
- Li, W.X.; Li, J.L.; Xu, Y.; Huang, Y.; Xu, S.Q.; Ou, Z.R.; Long, X.L.; Li, X.Y.; Liu, X.Y.; Xiao, Z.N.; et al. Expression of heat-resistant β-glucosidase in Escherichia coli and its application in the production of gardenia blue. Synth. Syst. Biotechnol. 2021, 6, 216–223. [Google Scholar] [CrossRef]
- Yang, Y.S.; Ding, Y.; Zhang, T. Biotransformation of geniposide into genipin by immobilized Trichoderma reesei and conformational study of genipin. Biomed. Res. Int. 2018, 2018, 2079195. [Google Scholar]
- Yang, D.; Zhou, M.; Wei, W.X.; Zhu, H.L.; Fan, X.W. Preparation of a genipin blue from egg protein and genipin. Nat. Prod. Res. 2012, 26, 765–769. [Google Scholar] [CrossRef]
- Hao, S.; Wang, J.; Li, S.; Shang, F.; Qin, Y.; Wu, T.T.; Bao, X.; Cao, Q.; Wang, C.T.; Sun, B.G. Preparation of gardenia red pigment and its antineoplastic activity in multiple tumor cells. Food Biosci. 2020, 35, 100582. [Google Scholar] [CrossRef]
- Basic Local Alignment Search Tool. Available online: http://www.ncbi.nlm.nih.gov/BLAST/ (accessed on 26 October 2020).
- Genus Leifsonia Taxonomy. Available online: https://www.bacterio.net/genus/leifsonia (accessed on 18 September 2020).
- Ouyang, Q.; Wang, P.; Huang, J.; Cai, J.B.; He, J.Y. Efficient enantioselective synthesis of (R)-[3,5-bis(trifluoromethyl)phenyl] ethanol by Leifsonia xyli CCTCC M 2010241 using isopropanol as co-substrate. J. Microbiol. Biotechnol. 2013, 23, 343–350. [Google Scholar] [CrossRef] [PubMed]
- Wang, P.; Cai, J.B.; Ouyang, Q.; He, J.Y.; Su, H.Z. Asymmetric biocatalytic reduction of 3,5-bis(trifluoromethyl) acetophenone to (1R)-[3,5-bis(trifluoromethyl)phenyl] ethanol using whole cells of newly isolated Leifsonia xyli HS0904. Appl Microbiol. Biotechnol. 2011, 90, 1897–1904. [Google Scholar] [CrossRef] [PubMed]
- Xu, M.M.; Sun, Q.; Su, J.; Wang, J.; Xu, C.; Zhang, T.; Sun, Q. Microbial transformation of geniposide in Gardenia jasminoides Ellis into genipin by Penicillium nigricans. Enzym. Microb. Technol. 2008, 42, 440–444. [Google Scholar] [CrossRef]
- Dai, Z.Y.; Aryal, U.K.; Shukla, A.; Qian, W.J.; Smith, R.D.; Magnuson, J.K.; Adney, W.S.; Beckham, G.T.; Brunecky, R.; Himmel, M.E.; et al. Impact of alg3 gene deletion on growth, development, pigment production, protein secretion, and functions of recombinant Trichoderma reesei cellobiohydrolases in Aspergillus niger. Fungal Genet. Biol. 2013, 61, 120–132. [Google Scholar] [CrossRef]
- Ray, A.C.; Eakin, R.E. Studies on the biosynthesis of aspergillin by Aspergillus niger. Appl. Microbiol. 1975, 30, 909–915. [Google Scholar] [CrossRef]
- Neri-Numa, I.A.; Angolini, C.F.F.; Bicas, J.L.; Ruiz, A.; Pastore, G.M. Iridoid blue-based pigments of Genipa americana L. (Rubiaceae) extract: Influence of pH and temperature on color stability and antioxidant capacity during in vitro simulated digestion. Food Chem. 2018, 263, 300–306. [Google Scholar] [CrossRef]
- Rehman, A.; Tong, Q.; Jafari, S.M.; Assadpour, E.; Shehzad, Q.; Aadil, R.M.; Iqbal, M.W.; Rashed, M.M.A.; Mushtaq, B.S.; Ashraf, W. Carotenoid-loaded nanocarriers: A comprehensive review. Adv. Colloid. Interface Sci. 2020, 275, 102048. [Google Scholar] [CrossRef]
- Zhang, M.; Lou, B.Y.; Zhang, Y.J.; Fu, H.X. Stability and antioxidant activity of anthocyanins from flowers of Rhododendron pulchrum sweet. Asian Agric. Res. 2018, 10, 88–92. [Google Scholar]
- Dictionary of Natural Products. Available online: https://dnp.chemnetbase.com/faces/chemical/ChemicalSearch.xhtml (accessed on 21 May 2021).

Publisher’s Note: MDPI stays neutral with regard to jurisdictional claims in published maps and institutional affiliations. |
© 2022 by the authors. Licensee MDPI, Basel, Switzerland. This article is an open access article distributed under the terms and conditions of the Creative Commons Attribution (CC BY) license (https://creativecommons.org/licenses/by/4.0/).
Share and Cite
He, Y.; Jiao, R.; Wang, X.; Wang, C.; Zhang, Z.; Xu, G. Transformation of Gardenia Yellow Waste Production into Gardenia Blue Pigment by Leifsonia sp. ZF2019 and Evaluation of Its Physicochemical Stability. Fermentation 2022, 8, 503. https://doi.org/10.3390/fermentation8100503
He Y, Jiao R, Wang X, Wang C, Zhang Z, Xu G. Transformation of Gardenia Yellow Waste Production into Gardenia Blue Pigment by Leifsonia sp. ZF2019 and Evaluation of Its Physicochemical Stability. Fermentation. 2022; 8(10):503. https://doi.org/10.3390/fermentation8100503
Chicago/Turabian StyleHe, Yi, Ronghu Jiao, Xi Wang, Chenxi Wang, Zhi Zhang, and Guangzhi Xu. 2022. "Transformation of Gardenia Yellow Waste Production into Gardenia Blue Pigment by Leifsonia sp. ZF2019 and Evaluation of Its Physicochemical Stability" Fermentation 8, no. 10: 503. https://doi.org/10.3390/fermentation8100503
APA StyleHe, Y., Jiao, R., Wang, X., Wang, C., Zhang, Z., & Xu, G. (2022). Transformation of Gardenia Yellow Waste Production into Gardenia Blue Pigment by Leifsonia sp. ZF2019 and Evaluation of Its Physicochemical Stability. Fermentation, 8(10), 503. https://doi.org/10.3390/fermentation8100503

